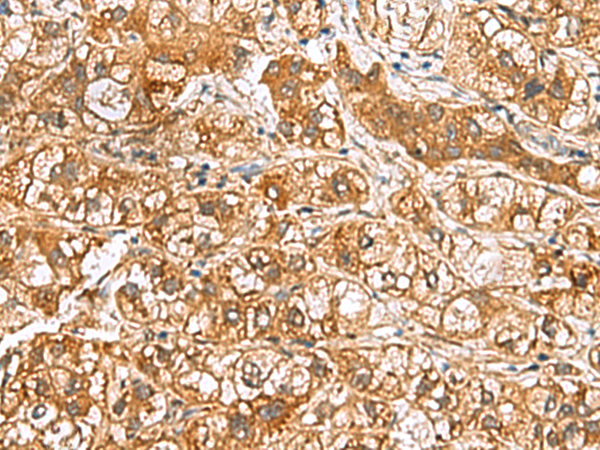
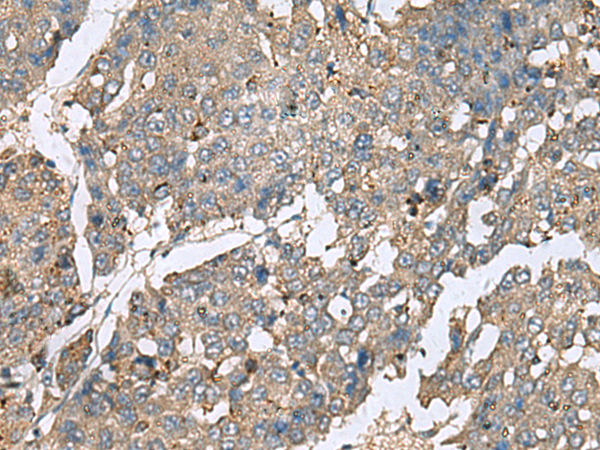

-
分类: 科研抗体货号: P10219别名: L3MBT; H-l(3)mbt-l应用: WB,IHC反应种属: Human, Mouse, Rat
-
分类: 科研抗体货号: P10218别名: MSL1v2; C2orf67应用: IHC反应种属: Human, Mouse
-
分类: 科研抗体货号: P10237别名: TIH1应用: IHC反应种属: Human, Mouse, Rat
-
分类: 科研抗体货号: P10217别名: AXCAM; BIG-2应用: IHC反应种属: Human, Mouse, Rat
-
分类: 科研抗体货号: P10252别名: S16应用: IHC反应种属: Human, Mouse, Rat
-
分类: 科研抗体货号: P10236别名: TIM16; MAGMAS; SMDMDM; TIMM16; CGI-136应用: WB,IHC反应种属: Human, Mouse
-
分类: 科研抗体货号: P10246别名: PSP; P14.5; UK114; HRSP12; hp14.5应用: WB,IHC反应种属: Human, Mouse, Rat
-
分类: 科研抗体货号: P10251别名: MOM1; PLA2; PLA2B; PLA2L; PLA2S; PLAS1; sPLA2应用: IHC反应种属: Human
-
分类: 科研抗体货号: P10235别名: PHP; PHP14; CGI-202; HSPC141; HEL-S-132P应用: WB,IHC反应种属: Human, Mouse
-
分类: 科研抗体货号: P10245别名: D55; hD55; NYDSP25应用: IHC反应种属: Human

鄂公网安备42018502007531号
鄂公网安备42018502007531号

